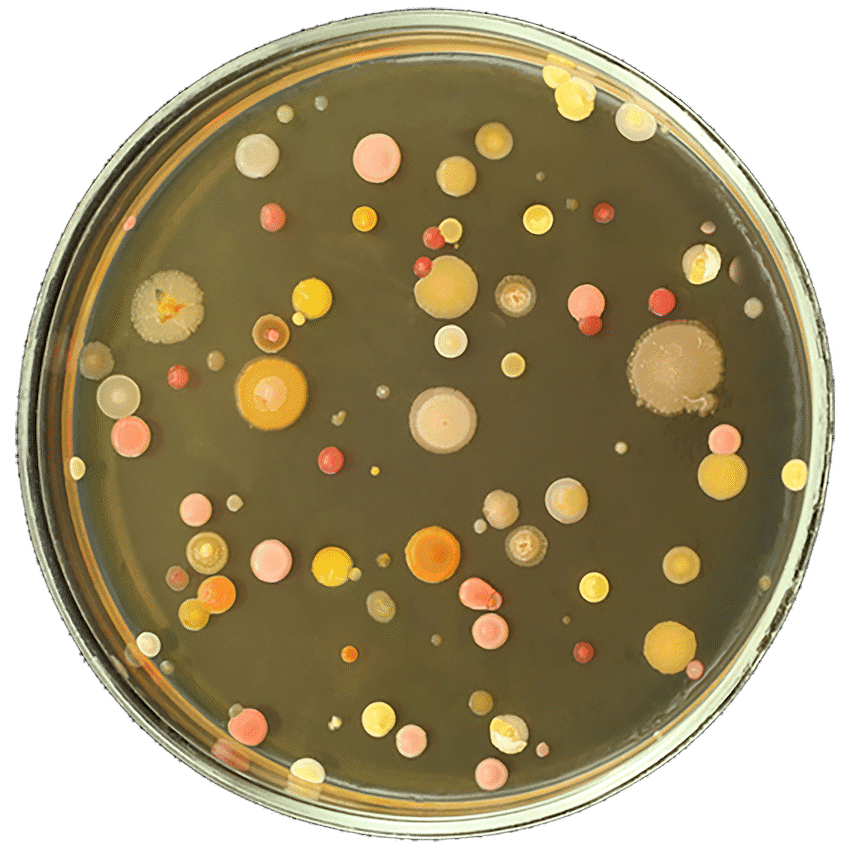
9 gross science experiments 5

Activities
9 gross science experiments
From R194.99 ex VAT
This science kit provides children with fun, practical learning through nine experiments. Kids can make slime, grow mould, and learn about insect lifecycles. It includes a clear, full-colour instruction manual, making it a memorable item for educational promotions.
This "9 gross science experiments" kit offers a memorable item for general promotional activities, appealing to families and educational initiatives. It provides children with hands-on engagement in science.
- Contains 9 different science experiments, allowing kids to make slime, grow mould, and understand insect lifecycles.
- Includes a clear, full-colour instruction manual for easy, step-by-step guidance.
- The kit measures L:7 cm x W:22 cm x H:29 cm, making it a compact educational item.
- Designed by Edu Matic, this educational toy has a negligible weight as per specifications.
This educational kit is a fine choice for branding efforts, providing a fun and engaging way to connect with a family audience through general promotional outreach.
Activities
This science kit provides children with fun, practical learning through nine experiments. Kids can make slime, grow mould, and learn about insect lifecycles. It includes a clear, full-colour instruction manual, making it a memorable item for educational promotions.
From R194.99 ex VAT
*Pricing excludes branding and setup fees
Quick Quote
Please select branded or unbranded.
R194.99 ex VAT each
R194.99 ex VAT
Enquire About This Product
Customer Reviews
4.9
Based on 1,442 Google reviews
Great service !!
I had such a pleasant experience with the Promo group! We had a big event and Richard helped me to make it a big success with making sure that all our stock was delivered in time. The quality of the quarter zip sweaters are great and we are very happy with the product, we will definitely be using the Promo group in the future.